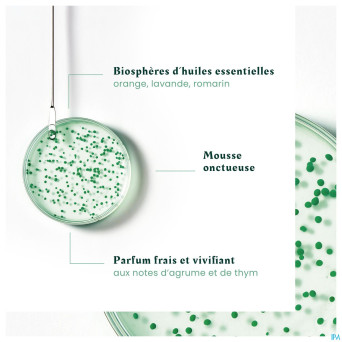
Furterer forticea sh fortifiant revitalisant 200ml
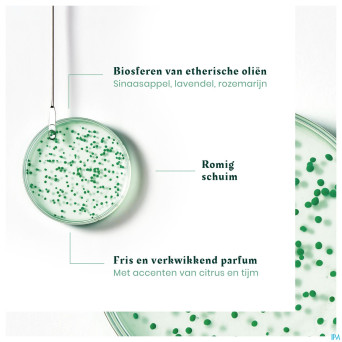
Furterer forticea sh fortifiant revitalisant 200ml

Furterer forticea sh fortifiant revitalisant 200ml
22,50 €
TTC
Furterer forticea versterkende revitalis. sh 200ml
 Garanties sécurité
Garanties sécurité
(à modifier dans le module "Réassurance")
 Politique de livraison
Politique de livraison
(à modifier dans le module "Réassurance")
 Politique retours
Politique retours
(à modifier dans le module "Réassurance")
Furterer forticea sh fortifiant revitalisant 200ml
Nom alternatif : Furterer forticea versterkende revitalis. sh 200ml
Code CNK : 4517058
Ce produit est un article pharmaceutique disponible en pharmacie. Veuillez consulter votre pharmacien pour plus d’informations.
CNK4517058
Pas de commentaires client pour le moment.